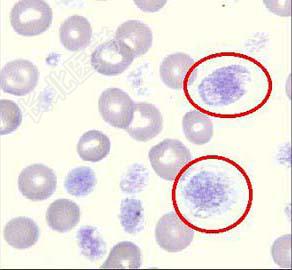

试题详情
- 单项选择题图所示是 ( )
A、中性粒细胞
B、红细胞
C、正常血小板
D、嗜酸性粒细胞
E、巨型血小板
关注下方微信公众号,搜题查看答案

热门试题
- 尿液中出现蜡样管型,主要见于 (
- 1、患者下一步应进行的检查有2、目前认为
- 粒细胞抗体可导致 ( )A、输血
- 符合渗出液特点的是 ( )A、比
- 自身输血优点有 ( )A、可避免
- ABO血型抗体一般分为二类,实际上都是
- 出现临床症状时,血小板的数量一般低于(
- 在尿液中呈菱形、黄色、暗棕色的结晶是
- 棘形红细胞指A、细胞大小改变B、血红蛋白
- 下列哪几组检查可能导致新生儿溶血 (
- 1、特征中支持胸腔积液为漏出液的有A、L
- 大红细胞的直径 ( )A、>
- 通常所说的血型是指 ( )A、红
- 卡波环现认为可能是( )A、核残余物
- 冷藏保存尿液的温度一般是 ( )
- 白细胞直方图中单个核细胞峰抬高增宽有可能
- 白细胞稀释液不能破坏的细胞是A、小红细胞
- 急性重型肝炎、急性磷中毒和白血病患者尿中
- 脑脊液采集的第一管用作下列哪项检查( )
- 关于尿1小时细胞排泄率的叙述,下列错误的